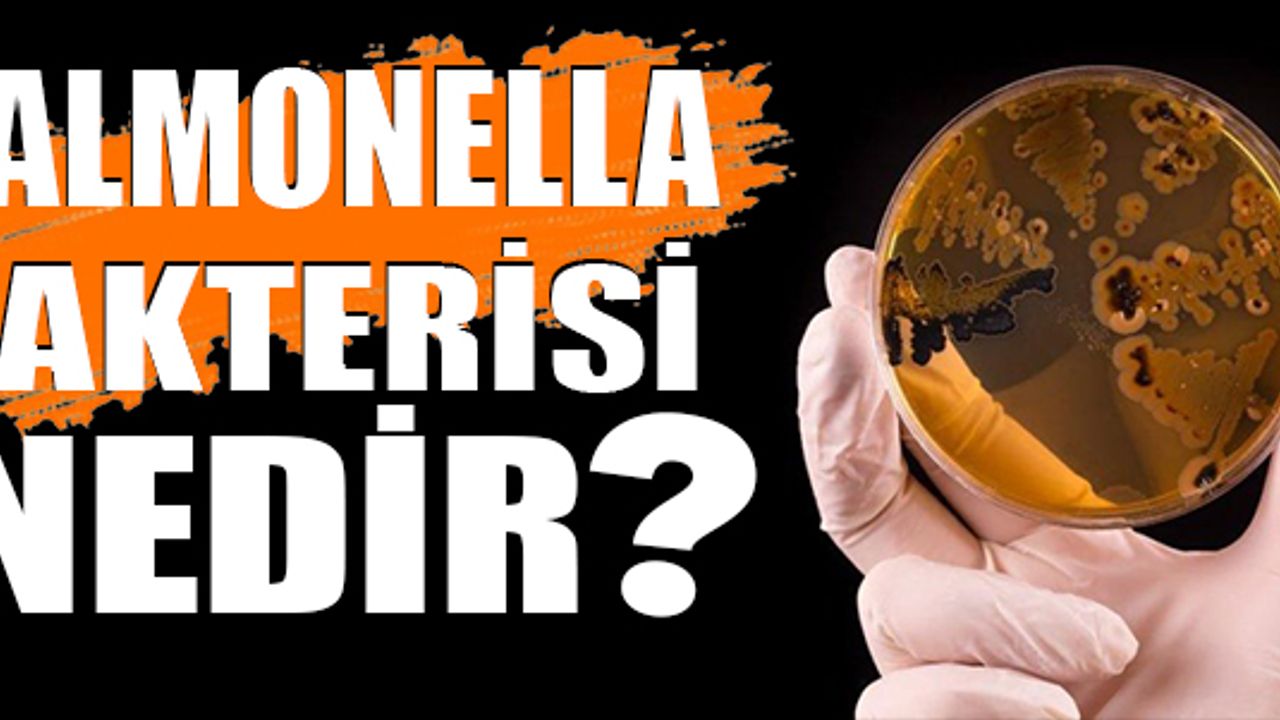

Salmonella bakterisi nedir, Salmonellozis hastalığı belirtileri nelerdir?
Salmonella bakterisi ve neden olduğu Salmonellozis hastalığı ile alakalı Bingöl Üniversitesi Gıda Tarım ve Hayvancılık Meslek Yüksekokulu ve Fen Bilimleri Enstitüsü Gıda Güvenliği anabilim dalında görev yapan Dr. Öğretim Üyesi Hakiye Aslan, Salmonella bakterisi hakkında açıklamalarda bulundu.
İngiltere'de 60'tan fazla çocukta Salmonella bakterisinin sebep olduğu gıda zehirlenmesi sonucu yetkililer harekete geçti. Kinder sürpriz yumurtalarda Salmonella bakterisi tespit edilmesinin ardından ülkede bazı parti mallar geri çağrıldı.
Bilindiği üzere ülkemizde de Tarım ve Orman Bakanlığı, Kinder marka Schoko Bons ürününün iki partisi için toplatma kararı almış, toplatılacak ürünlerin parti numaraları L329R03 ve L336R03, son tüketim tarihleri ise 08.07.2022 ve 15.07.2022 olarak açıklamıştı.
"Salmonella dünya genelinde yaygın bir bakteri türüdür"
Dr. Öğretim Üyesi Hakiye Aslan yaptığı açıklamada "Salmonella gıda kaynaklı hastalıklara ve salgınlara sebep olan en önemli bakterilerden biridir. Gıdaların üretiminde modern teknolojilerin kullanılmasına rağmen Salmonella salgınları dünya genelinde hala en önemli halk sağlığı problemi olmaya devam etmektedir. Avrupa Gıda Güvenliği Otoritesi (EFSA)'nın paylaştığı verilerine göre, Avrupa'da her yıl 91 bin'den fazla kişi Salmonella'ya yakalanmaktadır. EFSA'nın tahminlerine göre bu hastalık yılda 3 milyar Euro'dan daha fazla ekonomik kayba sebep olmaktadır." dedi.
"Tifo ve Gastroenteritis 'Salmonella' bakterisinin sebep olduğu en yaygın hastalıktır"
Aslan; "Salmonella'nın sebep olduğu hastalıklara salmonellozis adı verilmektedir. Bunlardan en yaygını tifo ve gastroenteritis'dir. Tifo hastalığının belirtileri, Salmonella tyhpi ile ulaşmış su ve gıdanın tüketiminden 1-4 hafta sonra hastalık belirtileri ortaya çıkmaktadır. Vücut ısısı yavaş yavaş 40°C'ye kadar yükselir, özellikle vücutta pembe lekeler oluşur ve baş ağrısı ve yüksek ateş meydana gelir. Kabızlık ve sonrasında kanlı ishal olur. Kusma ve karın ağrısı da olabilir. Salmonella enfeksiyonlarının sebep olduğu bir diğer rahatsızlık gastroenteritis'dir. Gastroenteritis, mide ve bağırsak enfeksiyonuna verilen isimdir. En yayın olanı budur. Salmonella bulaşmış gıdanın tüketiminden yaklaşık 12-72 saat sonra karın ağrısı, bulantı, kusma, baş ağrısı, halsizlik, ateş, üşüme-titreme, ishal gibi semptomlar görülmektedir. Bağışıklık sistemi güçlü bireyler herhangi bir tedaviye ihtiyaç duymadan birkaç gün içerisinde iyileşir. Ancak, bağışıklık sistemi zayıf kimseler, beş yaş altındaki çocuklar, bebekler ve yaşlılar için hastalık ağır seyredebilir ve tedavi edilmezler ise bu kimselerde hastalık ölümcül olabilir. Tedavi görmeyenlerde ölüm oranı %10-15 oranındadır." ifadelerine yer verdi.
"Salmonella'nın en önemli yaşam alanı hayvanların bağırsaklarıdır"
Salmonella'nın dünya genelinde yaygın olduğunu vurgulayan Aslan, özellikle bu bakterinin evcil ve çiftlik hayvanlarında bulunabileceği hususunda uyarılarda bulundu. Aslan, Salmonella dünyada yaygın olarak bulunan bir bakteri olup en önemli kaynağı hayvanların bağırsağıdır. (At, sığır, koyun, keçi, domuz ve kümes hayvanları, tavuk, hindi, ördek gibi) Çiftlik hayvanları, (Kedi, köpek, gibi) evcil hayvanlar ve (yılan, kaplumbağa, kuş gibi) yabani hayvanların bağırsağında bulunur. Hayvanlarda da enfeksiyona sebep olmaktadır.
"Salmonella vakasına yakalanmış bireyler iyileşse bile taşıyıcı olabilirler"
Aslan, Salmonella bakterisine enfekte olmuş bireylerin taşıyıcı olabileceğini belirterek; "Yine Salmonella enfeksiyonuna yakalanmış hasta kimseler ve iyileşen kimselerinde bağırsaklarında Salmonella bakterisi bulunmaktadır. Kişi iyileşse dahi aylarca bu bakteriyi taşıyıcı olarak çevreye, gıdaya ve kişiden kişiye oral veya fekal yolla bulaştırabilir." dedi.
"Salmonella hücreleri dışkı ile yayılmaktadır"
Aslan, "Salmonella hücreleri dışkı ile çevreye yayılmakta, doğada yıllarca canlılığını korumaktadır. Salmonella içeren dışkı veya lağım suları ile çevre ve su kaynaklarını kirlenmekte dolayısıyla bitkiler gibi gıda kaynaklarının da kirlenmesi söz konusu olmaktadır."
"Domuz, en önemli Salmonella kaynağıdır"
Aslan; "Salmonella vakalarında özellikle hayvansal gıdaların çok sayıda salgınla ilişkili olduğu bilinmektedir. En önemli Salmonella kaynağı olarak kümes hayvanlarının (tavuk, ördek, hindi) etleri ve yumurta başta gelmektedir. Kümes hayvanlarını dışında domuz en önemli Salmonella kaynağıdır. Salmonella enfeksiyonlarında yer alan diğer taşıyıcı gıdalar arasında sığır eti, süt ve süt ürünleri, kirli sulardan avlanan balık, Hindistan cevizi, kakao, çikolata ve baharatlar sayılabilir. Yine Salmonella bitkisel çok sayıda gıda da tespit edilmiştir." ifadelerine yer verdi.
"Salmonella ile kontamine olmasında en önemli iki kaynak toprak ve sudur"
Sulama suyunun bu hususta oldukça önemli olduğuna vurgu yapan Aslan, "Özellikle bitkilerin yetiştirilmesinde kanalizasyon suyu karışmış suların kullanılması veya ürünlerin kirli sular ile yıkanması sonucu Salmonella ile bulaş olmaktadır. Ayrıca, bitkilerin yetiştirilmesinde kullanılan hayvan kaynaklı işlenmemiş doğal gübrelerin Salmonella içermesi durumunda kontaminasyona sebep olmaktadır. Maydanoz, nane, marul, salatalık, yeşil soğan gibi taze tüketilen bitkisel gıdaların Salmonella ile kontamine olmasında en önemli iki kaynak toprak ve sudur." dedi.
"Salmonella bakterisi bulaştığı gıdada duyusal özellik noktasında bir değişim yapmaz"
Aslan, "Salmonella gıdaların tadında, kokusunda, görüntüsünde yani duyusal özelliklerinde herhangi bir değişikliğe sebep olmaz. Dolayısıyla tüketiciler gıdanın Salmonella ile bulaşı olup olmadığını bilemezler. Salmonella cinsine ait bütün türlerin patojen yani insanlarda hastalık yaptığı kabul edilmektedir. Dolayısıyla bağırsak orijinli patojen bir bakteri olan Salmonella'nın gıdalarda kesinlikle bulunmaması gerekmektedir." dedi.
"Endüstriyel üretimde Salmonella kontrollerinin yapılması çok önemli"
Aslan; "Salmonella kontrolünde mikroorganizmanın öldürülmesi, gıda kaynaklı hastalıkların önlenmesinde ve tüketiciler için güvenilir gıda temininin sağlanması açısından önemlidir. Yüksek sıcaklık uygulaması Salmonella'nın öldürülmesinde en iyi yöntemdir. Örneğin, çiğ sütün 72 ᵒC'de 15 saniyede pastörize edilmesi ya da sıvı yumurtanın 60ᵒC'de 3,5 dakika pastörizasyonu gibi uygulanan ısıl işlem ile güvenli ürün üretmek mümkün olmaktadır." ifadelerine yer verdi.
"Gıda ısıl işlem görmüş olsa bile denetim ve kontroller sağlanmalıdır"

Bingöl Üniversitesi Öğretim Üyesi Dr. Hakiye Aslan
Isıl işlem görmüş gıdalarda da bu bakterinin olabileceğini dile getiren Aslan, "Salmonella, tüketim öncesi ısıl işlem uygulanmış hayvansal gıdalara bulaşmış olabilir. Ülkemizde yasal düzenlemeler gereği ısıl işlem görmüş ve tüketime hazır ürünlerde Salmonella'nın tespit edilmesi durumunda bu ürünlerin satışına izin verilmez, ürünler satışa sunulmuş ise piyasadan toplatılarak imha edilir. Tüketici sağlığını korumak ve güvenilir gıda temini sağlamak amacıyla gıda üretimi yapan işletmelerin kurum içi denetim programları ile ürünlerindeki Salmonella varlığını kontrol etmeleri gerekmektedir." ifadelerini kullandı.
"Gıda işletiminde görev alan personellerin salgınına karşın sağlık kontrolleri yapılmalıdır"
Gıda üretimi hijyeni ve personelin sağlık kontrolü noktasında Aslan, "Gıdaların üretiminde ve hazırlanmasında hijyen kurallarına kesinlikle uyulmalıdır. Gıda işleme ve hazırlanmasında görev alan personel ateş, ishal, kusma gibi hastalık semptomları gösteriyor ise bu durumu amirine bildirmeli ve iyileşene kadar gıda üretiminde veya hazırlanmasında çalışmaması gerekmektedir." dedi.
"Arta kalan yemekler tüketilirken mutlaka 70 ᵒC'de ısıtıldıktan sona tüketilmelidir"
Tüketicilere Salmonella enfeksiyonlarından korunmaları için tavsiyelerde bulunan Aslan, "Özellikle arta kalan ve buzdolabında muhafaza edilen yemekler tekrar tüketilmek istenildiğinde iç sıcaklığının 70ᵒC veya üzeri sıcaklıkta olacak şekilde ısıtılması gerekmektedir. Çünkü eğer yemeğe Salmonella bulaşmış ise buzdolabında bekleme sırasında mikroorganizma ölmemekte canlılığını devam ettirmektedir. Sadece gıda içerisindeki mikroorganizma oda sıcaklığı ile kıyaslandığında buzdolabı sıcaklığında daha yavaş gelişmektedir. Bu sebepten dolayı arta kalan yemekler iyice ısıtıldıktan sonra tüketilmelidir. Hazırlanan yemekler iki saat içerisinde tüketilmeyecek ise buzdolabında 4ᵒC'ye soğutulması gerekmektedir." dedi.
"Süt ve Süt Ürünlerine dikkat"
Salgın konusunda önemli bir tehdit unsurunun da süt ve süt ürünleri olduğunu vurgulayan Aslan, "Çiğ süt ve çiğ sütten yapılmış ürünler Salmonella açısından güvenilir olmayabilir. Dolayısıyla ısıl işlem görmüş süt ve süt ürünlerini tüketmesi sağlığın korunması için daha uygun olur. Özellikle evcil hayvanlarla veya çiftlik hayvanlarıyla temas ettikten sonra ve tuvaletten sonra eller sabun ile iyice yıkanmalıdır. Yine piliç gibi Salmonella açısından riskli bir hayvansal gıdayı parçalamak için kullandığınız kesme tahtasını ve bıçağı deterjan ile iyice yıkadıktan sonra başka gıdaların hazırlanmasında kullanınız. El hijyenine özellikle dikkat edilmelidir. Çiğ olarak tüketilen meyve ve sebzeler iyice yıkandıktan sonra tüketilmelidir." dedi.
"Gıda üreticileri ve tüketicileri bilinçli olmalıdır"
Aslan son olarak; "Hem gıda üretiminden sorumlu personelin hem de tüketicilerin Salmonella açısından riskli gıdaların hazırlanması ve pişirilmesi konusunda eğitilmesi Salmonella enfeksiyonlarının önlenmesi açısından oldukça önemlidir." şeklinde konuştu.
(İLKHA)